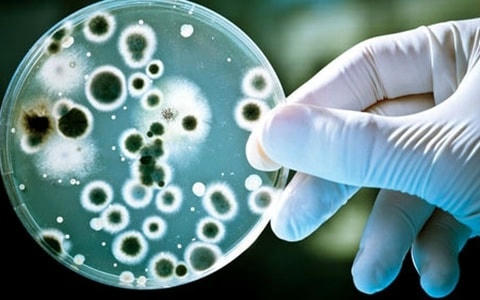

Đề phòng nhiễm khuẩn tụ cầu vàng
Vừa qua, hơn 70 học sinh một trường tiểu học ở Hà Nội đã bị ngộ độc sau khi ăn món thịt gà nhiễm khuẩn tụ cầu vàng. Vậy, vi khuẩn tụ cầu vàng là gì? Cơ chế lây nhiễm ra sao? Điều trị như thế nào?
Vi khuẩn sinh sôi nhanh và tạo ra độc tố
Theo tài liệu của Bộ Y tế, tụ cầu vàng tên khoa học là Staphylcocs aureus, có đường kính khoảng 0.8-1 micromet. Loại vi khuẩn này thường tập trung như chùm nho. Khi vi khuẩn này xâm nhập vào cơ thể qua các lỗ hở như một vết cắt hoặc phát ban, nó có thể gây ra nhiễm trùng sâu bên trong, rất nguy hiểm.
Vi khuẩn tụ cầu vàng thường cư trú trên da nhưng ít gây bệnh. Nhưng nếu có các vết xước, mụn trên người, kèm theo vệ sinh cá nhân không tốt, cơ thể có sức đề kháng yếu thì vi khuẩn tụ cầu dễ dàng xâm nhập gây các bệnh nguy hiểm. Tụ cầu vàng gây ra các tổn thương ngoài da như: chốc lở, viêm nang lông, các loại mụn nhọt, loét da. Thậm chí, có khi tạo nên các ổ áp xe nằm ngay dưới da gây đau đớn, sốt, sưng nề sung huyết làm đỏ cả một vùng da.
Khi nhiễm vào máu, tụ cầu cũng có thể gây nên các bệnh nặng như: áp xe phổi, viêm tủy xương, viêm nội tâm mạc hoặc gây viêm màng não mủ... Bệnh có thể gây nguy hiểm đến tính mạng của người bệnh và cũng có nguy cơ cao gây nhiễm khuẩn huyết.
Vi khuẩn tụ cầu vàng có thể sinh sôi nhanh và tạo ra độc tố khi thực phẩm không được bảo quản đúng cách.
Theo PGS.TS Trần Đáng - Chủ tịch Hiệp hội Thực phẩm chức năng Việt Nam, trong chủng vi khuẩn tụ cầu, phổ biến nhất là tụ cầu vàng. Biểu hiện của việc ăn phải thực phẩm nhiễm khuẩn tụ cầu vàng gồm: đau bụng, tiêu chảy, buồn nôn, suy nhược thần kinh, chóng mặt, nhức đầu… Những triệu chứng này thường xuất hiện trong vòng 2 - 4 giờ, chậm nhất đến 12 giờ. Các bệnh nhân bị ngộ độc do vi khuẩn tụ cầu vàng, với trường hợp nặng nếu không được điều trị kịp thời sẽ nguy hiểm đến tính mạng, có thể dẫn đến tử vong.
Cảnh giác khi chế biến thực phẩm
Theo Viện Y học ứng dụng Việt Nam, mọi người đều có thể bị ngộ độc khi ăn phải những thức ăn bị nhiễm tụ cầu vàng. Những thực phẩm dễ bị nhiễm tụ cầu vàng nhất là: Trứng, thịt gia súc, gia cầm, salad (có trứng, cá ngừ, thịt gà, khoai tây, mỳ ống), các loại bánh nướng có kem, các sản phẩm từ sữa…
Nguồn lây nhiễm tụ cầu vàng có thể do dụng cụ nấu nướng, chế biến thực phẩm không bảo đảm vệ sinh hay do quá trình lựa chọn, chế biến, bảo quản thực phẩm kém chất lượng.
Đặc biệt, PGS.TS Trần Đáng cảnh báo, tụ cầu vàng còn tồn tại rất nhiều trong cơ thể con người. Loại vi khuẩn này thường ẩn nấp trong mũi, miệng, mắt, tay, nách… Do đó, nguy cơ dễ nhiễm vào trong các loại thực phẩm.
“Khi chế biến, chia thực phẩm, mỗi người dân phải giữ gìn vệ sinh đảm bảo an toàn thực phẩm, đeo găng tay, khẩu trang, mặc quần áo bảo hộ. Người tiêu dùng khi mua thực phẩm phải chọn cẩn thận, bảo quản để thực phẩm không bị ôi thiu, ô nhiễm. Dụng cụ chế biến thực phẩm cũng phải được giữ vệ sinh sạch sẽ” - PGS.TS Trần Đáng khuyến cáo.
Trong khi đó, theo BS Nguyễn Huy Hoàng - Trung tâm Nhiệt đới Việt - Nga, vi khuẩn tụ cầu vàng hay gặp, thường ký sinh trên da, niêm mạc người. Khi nhiễm vào thực phẩm, đặc biệt là thịt, cá, sữa... sẽ có thể tạo ra ngoại độc tố ruột là enterotoxin. Ngoại độc tố của tụ cầu vàng nguy hiểm vì nó bền vững với nhiệt độ, phải mất hơn 1 tiếng ở nhiệt độ 100 độ C mới phân hủy được độc tố. Đáng nói, độc tố này lại không làm thay đổi mùi vị của thức ăn.
Điều trị như thế nào?
Khi bị tụ cầu vàng, bác sĩ sẽ điều trị bằng cách cho bệnh nhân sử dụng kháng sinh. Tuy nhiên, ngày này do việc sử dụng kháng sinh tùy tiện, không theo chỉ định đã gây nên tình trạng kháng kháng sinh khiến cho việc điều trị các nhiễm trùng gây nên bởi tụ cầu vàng trở nên khó khăn.
Theo BS Nguyễn Huy Hoàng, cách điều trị khi bị nhiễm khuẩn tụ cầu vàng là bù dịch và cân bằng điện giải, điều trị triệu chứng, thường bệnh nhân hồi phục sau 1-2 ngày. Bệnh cũng có thể gây biến chứng nặng như trụy tim mạch, sốc… trên các trẻ suy dinh dưỡng, sức đề kháng kém hoặc người già yếu, nhiều bệnh nền.
Tụ cầu vàng thậm chí còn được coi là một loại “siêu vi khuẩn” do hiện nay nó đã trở nên đề kháng với rất nhiều loại kháng sinh mà trước kia có thể sử dụng để tiêu diệt nó trong các bệnh viện, trung tâm y tế…